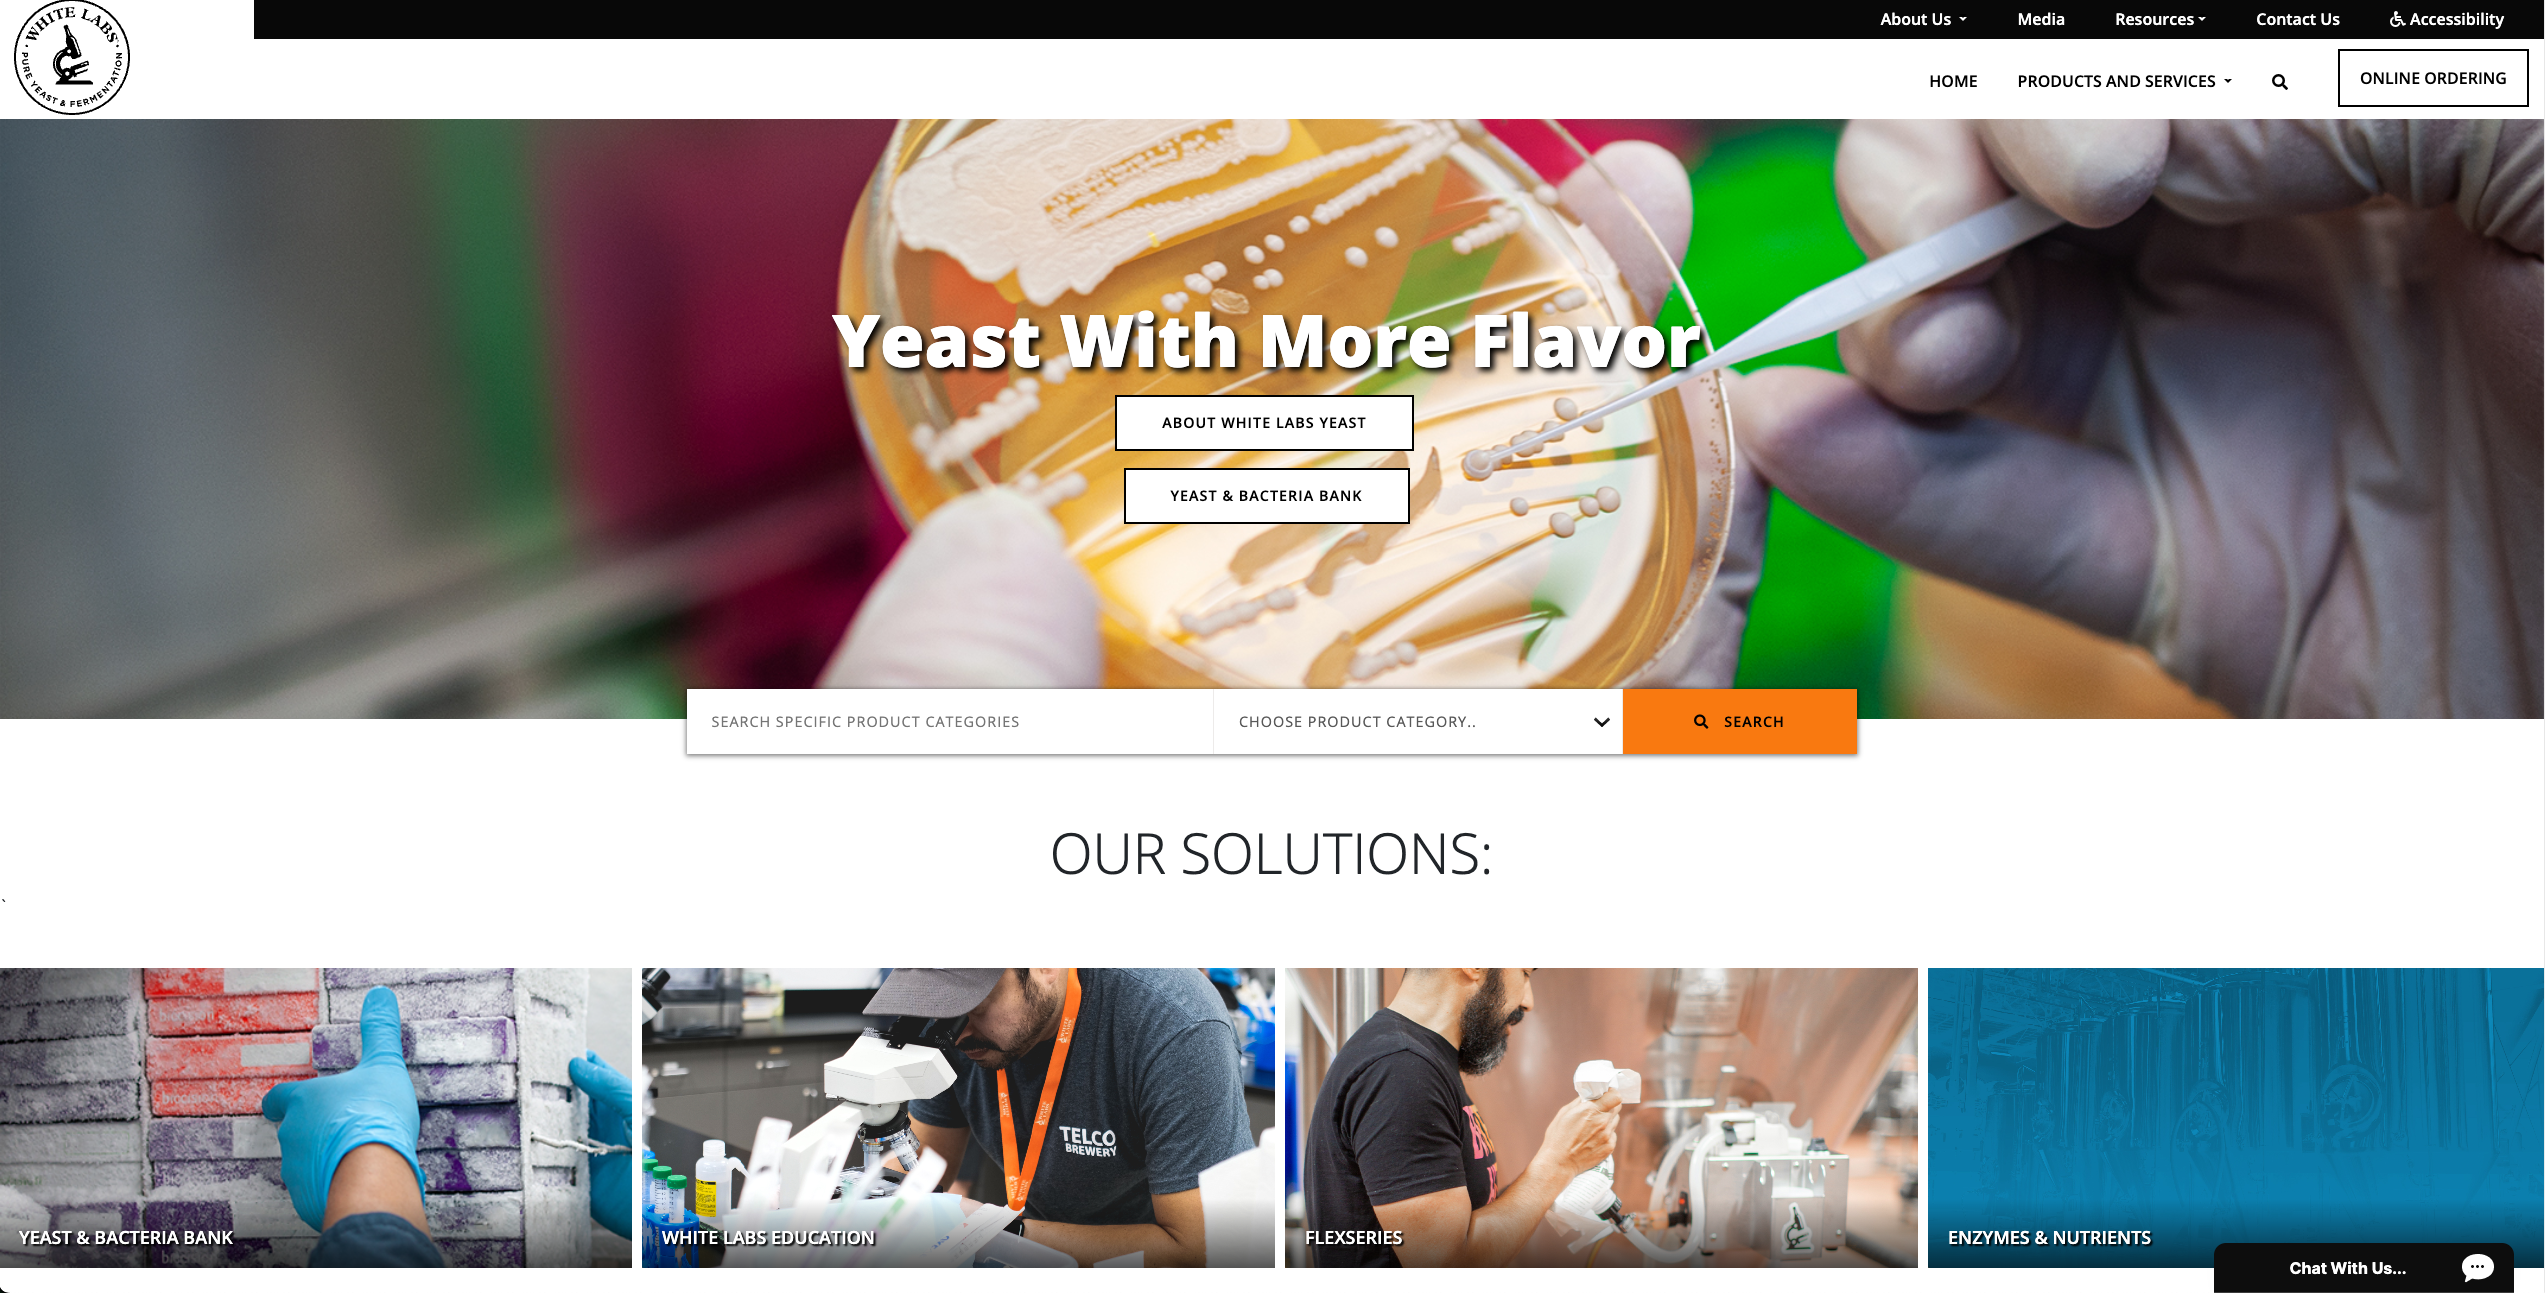

+20%
Increase in Traffic
3%
Conversion Rate
2x
Conversions
White Labs is a trusted leader in the fermentation industry, providing high-quality yeast strains, fermentation products, and technical expertise to breweries, wineries, distilleries, and home brewers worldwide. Their diverse product portfolio includes specialty yeast strains, fermentation nutrients, and technical services that serve both commercial operations and individual enthusiasts in the growing craft beverage market.
Challenges
The fermentation and yeast industry presents unique challenges in digital marketing, particularly when serving both B2B commercial clients and D2C home brewing enthusiasts. White Labs faced a critical situation where Google algorithm updates had significantly impacted their organic visibility, leading to decreased product discoverability and organic revenue. The challenge was not just about recovering lost rankings, but about building a more resilient SEO foundation that could withstand future algorithm changes while serving their diverse customer base.
Objectives:
- Recover lost product keyword rankings and organic visibility following Google algorithm updates
- Restore organic traffic levels to pre-update performance
- Improve website technical foundation to prevent future ranking losses
- Establish sustainable SEO growth strategy for long-term organic success
- Maintain visibility across both B2B and D2C search intent and customer journeys
Initial Challenges:
- Significant drop in organic visibility following Google algorithm updates
- Decreased product discoverability impacting both B2B and D2C revenue streams
- Technical website issues that may have contributed to ranking losses
- Need for comprehensive SEO audit and recovery strategy
- Competitive market with established players in fermentation and yeast products
- Diverse customer base requiring different content and optimization approaches
Solutions
Our SEO recovery strategy centered on the principle that algorithm updates often reveal underlying technical and content issues that need to be addressed systematically. We focused on understanding the specific impact of Google's updates on White Labs' product pages and technical infrastructure, then implemented a comprehensive recovery plan that addressed both immediate ranking issues and long-term sustainability.
1. Comprehensive Technical SEO Audit & Recovery
2. Strategic Keyword Recovery & Content Optimization
3. Content Strategy & Authority Building
4. Long-term Partnership & Continuous Optimization


Result
The SEO recovery strategy delivered exceptional results that exceeded expectations, demonstrating the power of systematic SEO recovery and long-term partnership in competitive e-commerce markets. What made these results particularly impressive was the speed of recovery and the establishment of sustainable growth foundations that positioned White Labs for continued organic success.
- 20% Organic Traffic Increase
- 3% Conversion Rate Achievement
- 2x Conversions (E-commerce Purchases)
- Product Keyword Rankings Recovered
- Sustainable Growth Foundation Established
Summary
SEO recovery from algorithm updates is not just about restoring lost rankings, but about building a stronger, more resilient organic presence. White Labs' 20% traffic increase, 3% conversion rate achievement, and doubled e-commerce conversions were achieved through systematic technical optimization, strategic content development, and long-term partnership approach.
Mozart
Software Developer